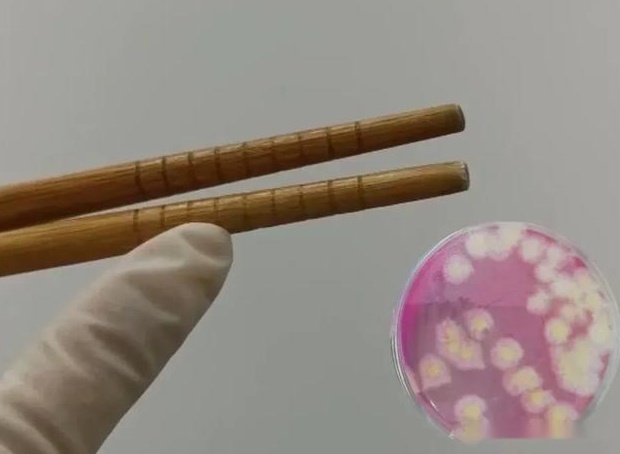
全国统一的“开水烫碗”，究竟烫了个啥？

在外就餐,“开水烫碗”似乎已经成了大多数人默认的餐前“统一仪式”:热水杀菌消毒,吃饭更安心。

底图来源:网络
事实真的这样吗?当你摸着略烫手的碗边暗自欣慰时,细菌或许正躲在角落冷笑:"就这?"
本期白泽就带大家一探“开水烫碗”的真相,聊聊关于餐具卫生的问题!
一、开水烫碗真能杀菌?
温度和时间是硬门槛
根据《GB14934-2016消毒餐(饮)具》中的规定,餐具中的主要微生物检测项目为大肠杆菌和沙门氏菌,均为不得检出。

图源:腾讯医典
■大肠杆菌
大肠菌群被用作判断食品是否被粪便污染的重要指标,反映食品被人或动物肠道菌污染及污染程度的可能性。使用了被致病性大肠杆菌污染的餐具,可能会导致腹痛、腹泻、恶心呕吐、便血等症状。
如果想要消灭大肠杆菌,需要满足温度在75℃以上,时间达1分钟这个条件,才可将其杀死。

■ 沙门氏菌
被它感染后轻则腹痛、腹泻、呕吐,严重会导致死亡。不过沙门氏菌不耐热,100℃下加热会立即死亡。如果加热温度偏低,则需延长加热时间,当温度在70℃时,需持续加热5分钟,如果仅有60℃时,则需要15分钟才会将沙门氏菌消灭。
但一般在外就餐时,餐厅提供的水未必是开水,且为了避免烫伤消费者,可能都不到60℃,用来冲洗餐具的时候温度还会进一步下降。
因此,关于“开水烫碗”这件事。如果能保证是刚烧开的 100℃ 热水,冲烫餐具 30 秒,还是能有效地去除一部分细菌。但餐馆的水大多数情况下都不满足这样的温度,冲洗时间也不够,所以几乎没啥大作用。

底图来源:网络
二、外出就餐“防坑”指南,
守护饮食健康
划重点:开水烫碗,烫比不烫好,想要更杀菌要保证足够的温度和时间哦,烫碗虽然充满仪式感,但也是有意义的卫生行为。除此之外,在外就餐如何保证饮食安全呢?赶快记好这份“防坑”指南!
■ 选择正规餐厅
正规餐厅的卫生情况更有保障,餐具卫生合格率较高。
■辨别消毒餐具是否合格
很多餐厅的餐具都是包装好的,使用前可仔细观察塑封膜是否干净、完整,包装上是否清晰标注了厂家地址、联系电话、保质期。餐具表面是否光洁,不得有附着物、无杂质、无油渍、无泡沫、无异味。
图源:上海市消保委官网
三、家庭厨房如何保持餐具卫生?
做好五点
民以食为天,吃饭是头等大事!除了在外就餐的餐具卫生外,家庭厨房的餐具安全也时刻注意!
-餐具定期消毒
-筷子定期更换
-刷碗后碗口朝下放置
-砧板悬挂晾干
-不要用洗碗布擦餐具
参考来源:科普中国、央视新闻、澎湃新闻、江苏疾控


点击右上角![]() 微信好友
微信好友
 朋友圈
朋友圈

点击浏览器下方“ ”分享微信好友Safari浏览器请点击“
”分享微信好友Safari浏览器请点击“ ”按钮
”按钮

点击右上角 QQ
QQ

点击浏览器下方“ ”分享QQ好友Safari浏览器请点击“
”分享QQ好友Safari浏览器请点击“ ”按钮
”按钮
